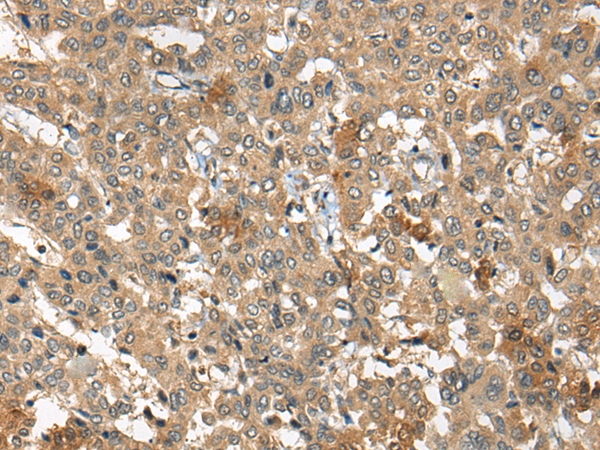

中文名稱:兔抗ARCN1多克隆抗體
|
Background: |
This gene maps in a region, which include the mixed lineage leukemia and Friend leukemia virus integration 1 genes, where multiple disease-associated chromosome translocations occur. It is an intracellular protein. Archain sequences are well conserved among eukaryotes and this protein may play a fundamental role in eukaryotic cell biology. It has similarities to heat shock proteins and clathrin-associated proteins, and may be involved in vesicle structure or trafficking. |
|
Applications: |
ELISA, IHC |
|
Name of antibody: |
ARCN1 |
|
Immunogen: |
Synthetic peptide of human ARCN1 |
|
Full name: |
archain 1 |
|
Synonyms: |
COPD |
|
SwissProt: |
P48444 |
|
ELISA Recommended dilution: |
5000-10000 |
|
IHC positive control: |
Human liver cancer |
|
IHC Recommend dilution: |
25-100 |
購(gòu)物車
購(gòu)物車 幫助
幫助
 021-54845833/15800441009
021-54845833/15800441009
